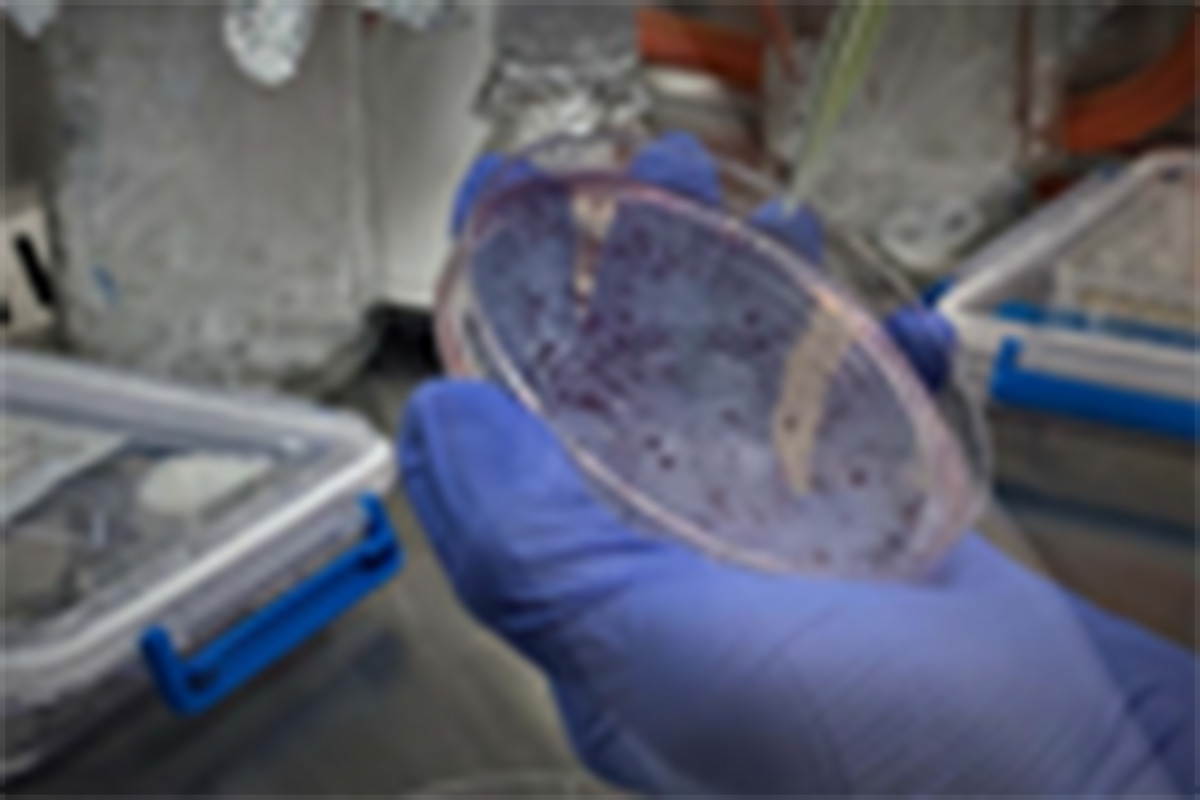

生物薬品科学
大学院生・学部配属生
| 大学院生 | |
|---|---|
| 博士課程(前期) | 5名 |
| 学部配属生 | |
|---|---|
| 4年生 | 4名 |
研究内容
- 上部消化管におけるPro含有ペプチドの作用に関する研究
- 胃粘膜細胞における薬物の毒性試験(細胞選択性の高い薬物の探索)
- ウレアーゼ阻害物質、H.Pyloriに対する抗菌活性物質の探索
- 胃粘膜保護に関する研究
- アミノ酸トランスポーターを介する疾患の制御
- ZIPトランスポーターを介する鉄・亜鉛シグナルの解明
- 上皮細胞における物質輸送の解明

細胞内のカルシウムイオン濃度を制御する。
細胞が刺激を受けると細胞内のカルシウムイオン濃度が上昇し興奮します。胃酸や消化酵素(ペプシノーゲン)を分泌する細胞の細胞内カルシウムイオン濃度上昇を抑えてくれる物質があれば、胸焼けや胃粘膜の荒れが抑えられます。私たちの研究室には、細胞内カルシウムイオンの変化を観察できる顕微鏡システムが有り、様々な実験に応用できます。
細胞が刺激を受けると細胞内のカルシウムイオン濃度が上昇し興奮します。胃酸や消化酵素(ペプシノーゲン)を分泌する細胞の細胞内カルシウムイオン濃度上昇を抑えてくれる物質があれば、胸焼けや胃粘膜の荒れが抑えられます。私たちの研究室には、細胞内カルシウムイオンの変化を観察できる顕微鏡システムが有り、様々な実験に応用できます。
胃の荒れを抑え、胃の運動を整える。
胃潰瘍は胃酸やペプシンなどの攻撃因子と粘液や粘膜の血流などの防御因子のバランスが崩れることで発生すると考えられています。私たちの研究室では、ある短鎖ペプチドの抗潰瘍効果を研究しています。また、胃の運動に関与するホルモンの作用機序について研究もしています。胃の調子を整えておかないとご飯も美味しく食べられませんよね。
胃潰瘍は胃酸やペプシンなどの攻撃因子と粘液や粘膜の血流などの防御因子のバランスが崩れることで発生すると考えられています。私たちの研究室では、ある短鎖ペプチドの抗潰瘍効果を研究しています。また、胃の運動に関与するホルモンの作用機序について研究もしています。胃の調子を整えておかないとご飯も美味しく食べられませんよね。

天然物資源の中からピロリ菌に効く成分を
探します。
ピロリ菌は、胃潰瘍や胃炎の原因菌として知られています。日本人はピロリ菌の感染者が多く、50歳代では約半分の人が感染していると言われています。胃癌のリスクも高くなることから、除菌が推奨されています。城西大学薬学部薬科学科には天然物化学研究室があります。共同研究することで、ピロリ菌に効く成分を探しています。
探します。
ピロリ菌は、胃潰瘍や胃炎の原因菌として知られています。日本人はピロリ菌の感染者が多く、50歳代では約半分の人が感染していると言われています。胃癌のリスクも高くなることから、除菌が推奨されています。城西大学薬学部薬科学科には天然物化学研究室があります。共同研究することで、ピロリ菌に効く成分を探しています。
学生への対応
- 研究を通して、なぜ?と自分で疑問に思える科学者としての基礎知識を身につけ、その疑問に対して自ら解決する手だてを構成できるような指導を心がけています。



